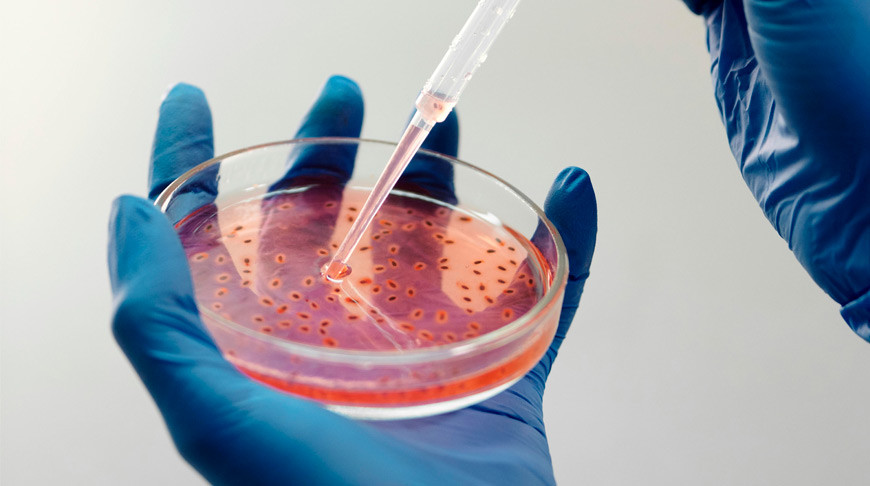
Онколог объяснил когда проводят профилактическую мастэктомию

Онколог объяснил когда проводят профилактическую мастэктомию
Профилактическая мастэктомия может рассматриваться у женщин с очень высоким риском развития рака молочной железы. Об этом рассказал врач-онколог-хирург Минского городского клинического онкологического центра Александр Гладышев.
Кому прежде всего грозит высокий риск
По словам специалиста, в группе риска находятся женщины с генетически обусловленной опухолью молочной железы. Кроме того, повышенное внимание требуется тем, у кого есть отягощенный семейный анамнез.
Прежде всего, речь идет о случаях рака молочной железы, яичников и ободочной кишки у близких родственников. Такие заболевания могут входить в наследственные синдромы.
Какие мутации особенно важны
Для оценки риска используют генетическую диагностику. В частности, врачи обращают внимание на мутации в генах BRCA1 и BRCA2.
Если такие мутации выявлены, риск заболеть раком молочной железы может превышать средний популяционный уровень на 40–80%. Поэтому в таких случаях действительно рассматривают профилактические вмешательства.
Когда проводят профилактическую мастэктомию
Александр Гладышев подчеркнул, что вопрос о профилактических операциях в медицине давно изучен. Следовательно, для таких вмешательств уже существуют определенные показания.
Если риск развития болезни очень высок, профилактическая мастэктомия может стать способом снизить вероятность заболевания в будущем.
Какие внешние факторы повышают риск
Специалист также объяснил, что на развитие рака молочной железы влияют экзогенные факторы. Это все, что окружает человека извне.
К ним относятся загрязнение окружающей среды, ионизирующая радиация и вредные привычки. По возможности такие факторы стоит исключать из повседневной жизни, чтобы уменьшить канцерогенное воздействие на организм.
Какие внутренние факторы влияют на развитие болезни
Не менее важны и эндогенные факторы. Это те причины, которые связаны с состоянием организма.
По словам врача, одним из значимых факторов остается ожирение и избыточная масса тела. Кроме того, риск повышает гиперэстрогения, когда в организме увеличивается влияние эстрогенов.
Какие заболевания требуют внимания
На риск развития рака молочной железы могут влиять и эндокринные нарушения. В частности, речь идет о заболеваниях щитовидной железы, например гипотиреозе.
Также значение имеют болезни гипоталамо-гипофизарной системы и надпочечников. Кроме того, врач упомянул гинекологические заболевания, включая дисфункции яичников и хронические болезни мочеполовой системы.
Все эти состояния могут менять гормональный фон. А именно гормональные нарушения, как подчеркнул специалист, повышают риск развития рака молочной железы.
Почему важно знать о факторах риска
Ранняя оценка риска помогает вовремя выбрать правильную тактику наблюдения и профилактики. В некоторых случаях это может быть регулярный контроль, а в других — более серьезные профилактические меры.
Поэтому женщинам с семейной историей онкологических заболеваний или эндокринными нарушениями важно консультироваться со специалистами и не откладывать диагностику.
Источник: Белта